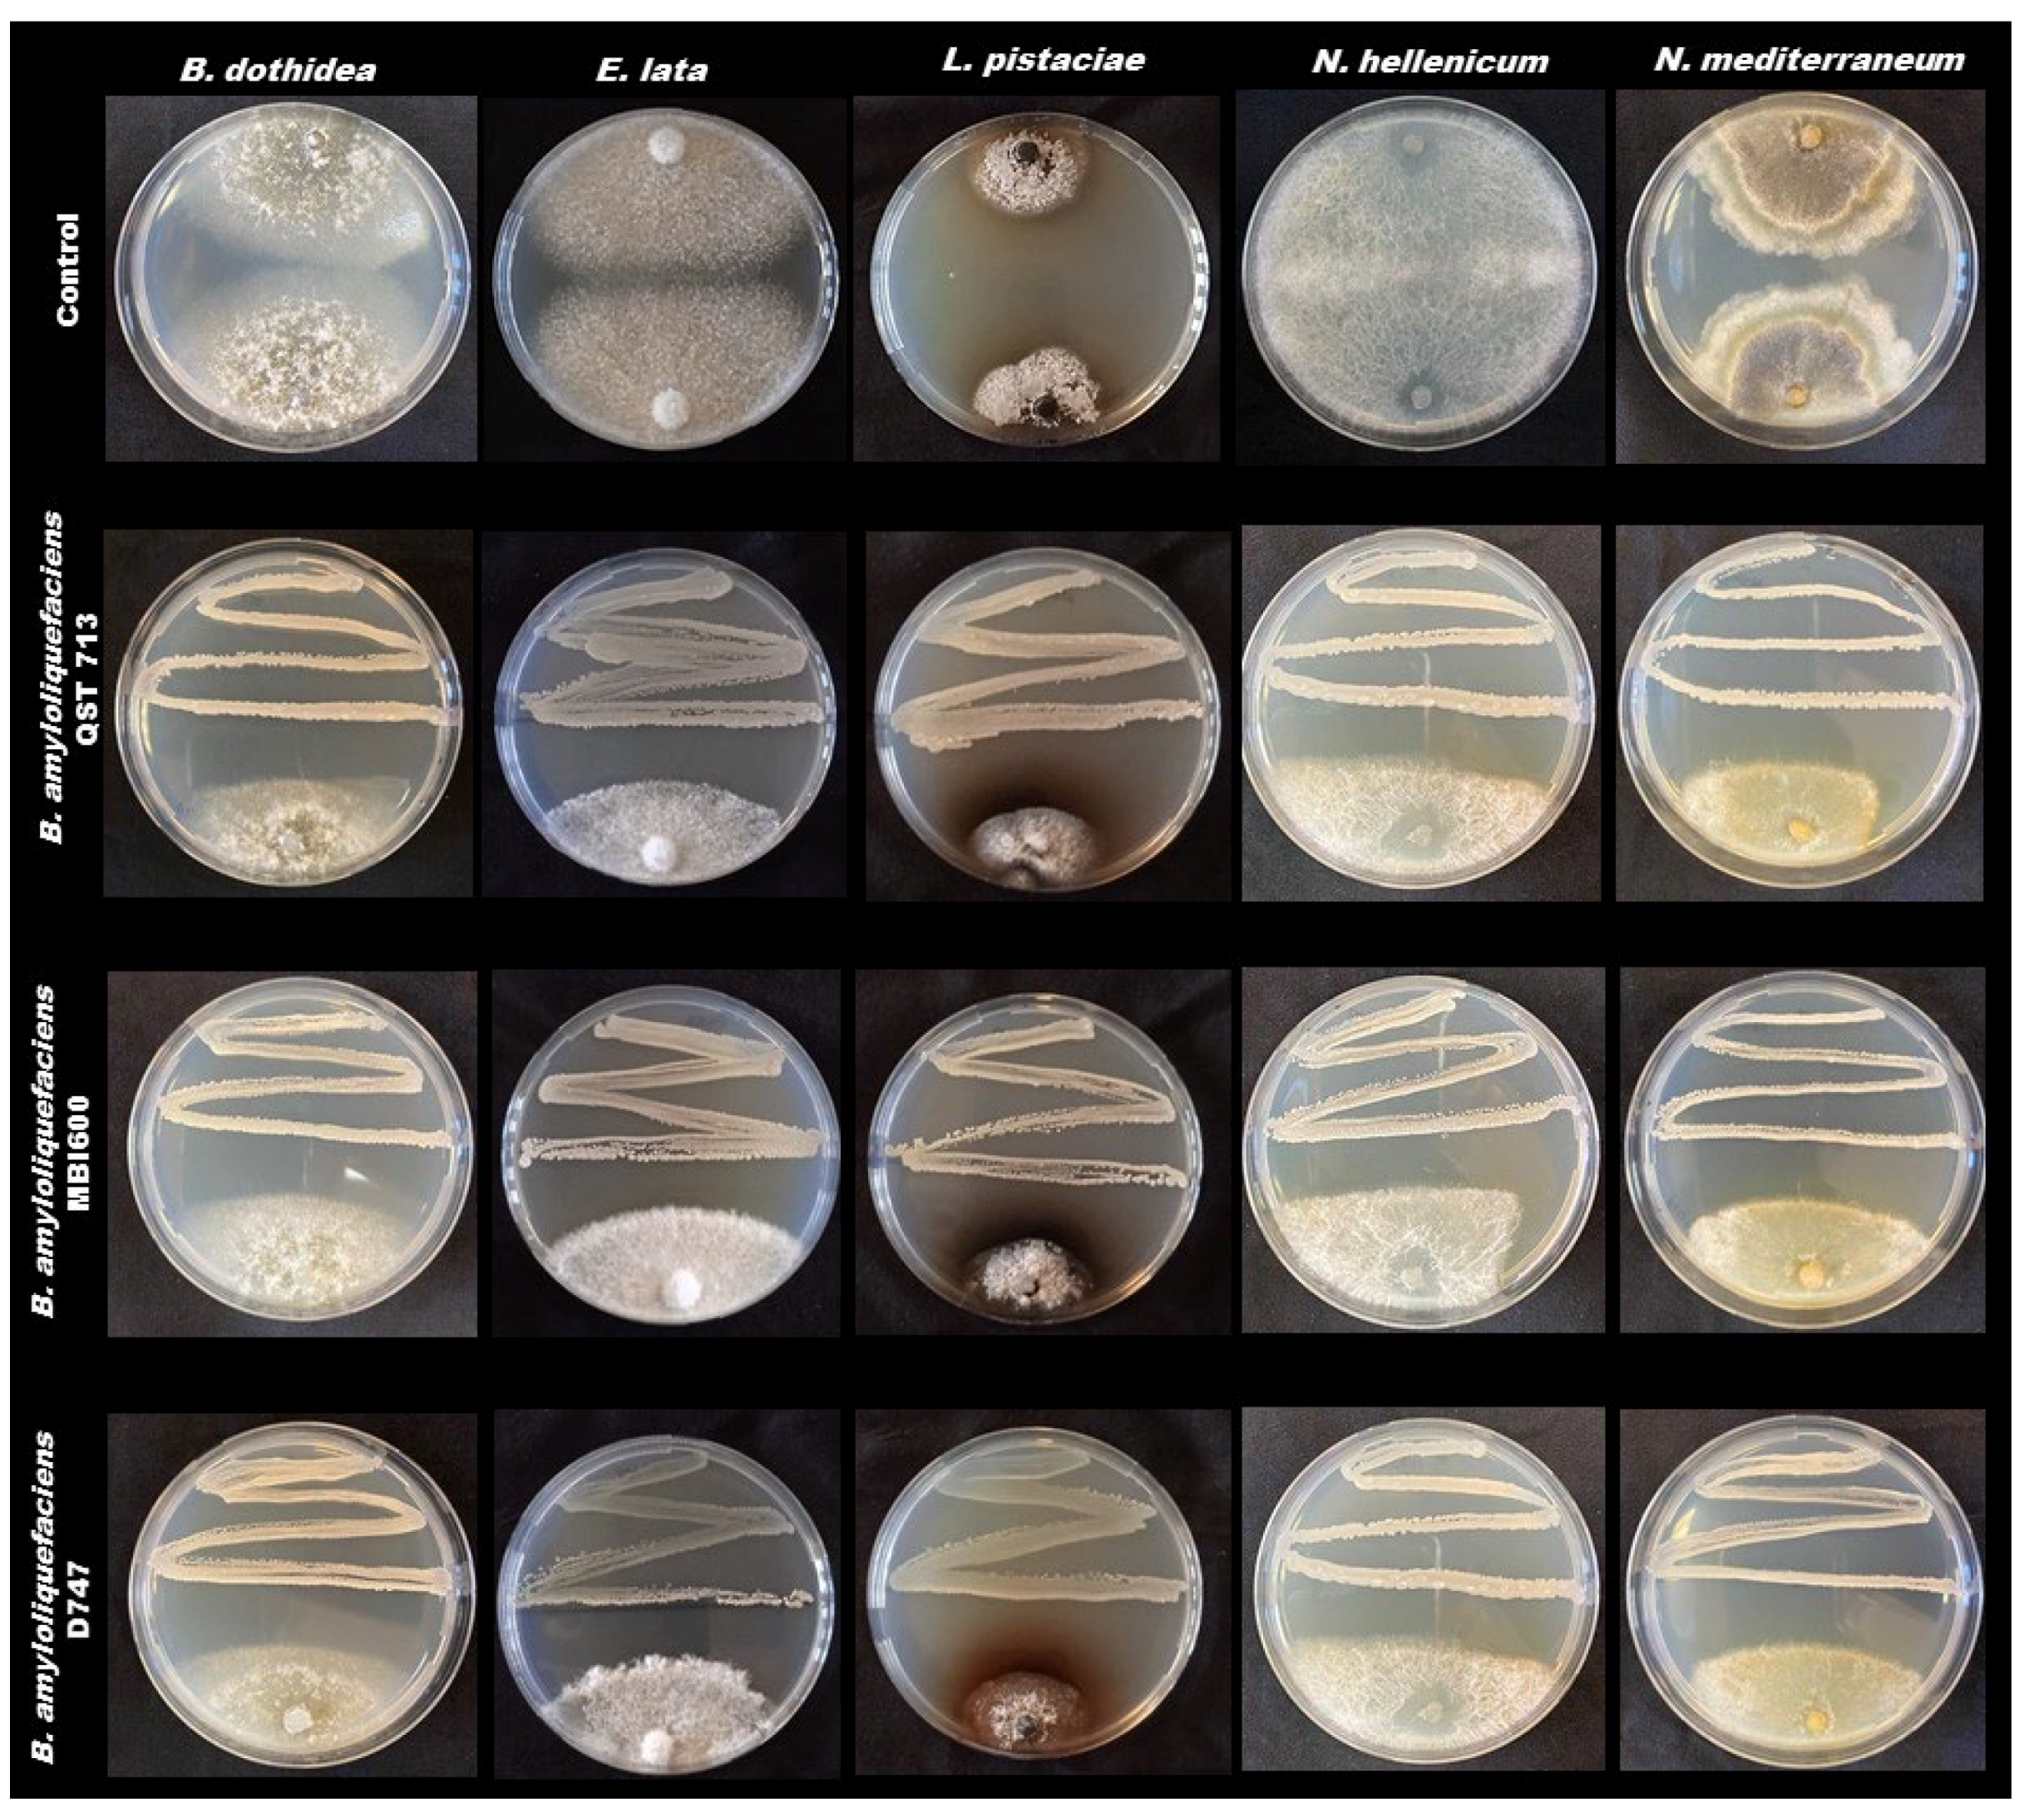
Pathogens 11 00829 g002 550

Potential Role of Biocontrol Agents for Sustainable Management of Fungal Pathogens Causing Canker and Fruit Rot of Pistachio in Italy
Abstract
:1. Introduction
2. Results
2.1. In Vitro Dual Culture Assays
2.2. Detached Twig Assays
2.3. Detached Fruit Assays
3. Discussion
4. Materials and Methods
4.1. Fungal Pathogens and Biocontrol Agents
4.2. In Vitro Dual Culture Assays
4.3. Detached Twig Assays
4.4. Detached Fruit Assays
4.5. Data Analysis
Author Contributions
Funding
Institutional Review Board Statement
Informed Consent Statement
Data Availability Statement
Acknowledgments
Conflicts of Interest
References
- Available online: https://www.fao.org/faostat/en/#data/QCL/visualize (accessed on 1 December 2021).
- Barone, E.; Marra, F.P. The Pistachio Industry in Italy: Current situation and prospects. Nucis 2004, 12, 16–19. [Google Scholar]
- Commission Regulation. European Union Regulation No. 21/2010 of 12 January 2010 Entering a name in the Register of Protected Designations of Origin and Protected Geographical Indications, Pistacchio Verde di Bronte (PDO). Off. J. Eur. Union 2010, L8, 3–4. [Google Scholar]
- Marino, G.; Marra, F.P. Horticultural management of Italian Pistachio orchard systems: Current limitations and future prospective. Italus Hortus. 2019, 26, 14–26. [Google Scholar] [CrossRef]
- Aiello, D.; Polizzi, G.; Gusella, G.; Fiorenza, A.; Guarnaccia, V. Characterization of Eutypa lata and Cytospora pistaciae causing dieback and canker of pistachio in Italy. Phytopathol. Mediterr. 2019, 58, 699–706. [Google Scholar]
- Vitale, S.; Aiello, D.; Guarnaccia, V.; Luongo, L.; Galli, M.; Crous, P.W.; Polizzi, G.; Belisario, A.; Voglmayr, H. Liberomyces pistaciae sp. nov., the causal agent of pistachio cankers and decline in Italy. MycoKeys 2018, 40, 29–51. [Google Scholar] [CrossRef] [Green Version]
- Voglmayr, H.; Aguirre-Hudson, M.B.; Wagner, H.G.; Tello, S.; Jaklitsch, W.M. Lichens or endophytes? The enigmatic genus Leptosillia in the Leptosilliaceae fam. nov. (Xylariales), and Furfurella gen. nov. (Delonicicolaceae). Persoonia 2019, 42, 228–260. [Google Scholar] [CrossRef] [Green Version]
- Aiello, D.; Gulisano, S.; Gusella, G.; Polizzi, G.; Guarnaccia, V. First report of fruit blight caused by Arthrinium xenocordella on Pistacia vera in Italy. Plant Dis. 2018, 102, 1853. [Google Scholar] [CrossRef]
- Mirabile, G.; Torta, L. Pistachio fruits rust caused by Tuberculina persicina (Ditmar) Sacc., anamorph of Helicobasidium purpureum (Tul.) Pat. J. Plant Dis. Protect. 2020, 127, 597–600. [Google Scholar] [CrossRef]
- Gusella, G.; Aiello, D.; Michailides, T.J.; Polizzi, G. Update of pistachio leaf spot caused by Septoria pistaciarum in light of new taxonomic advances in Italy. Fungal Biol. 2021, 125, 962–970. [Google Scholar] [CrossRef]
- Gusella, G.; Lawrence, D.P.; Aiello, D.; Luo, Y.; Polizzi, G.; Michailides, T. Etiology of Botryosphaeria Panicle and Shoot Blight of Pistachio (Pistacia vera) caused by Botryosphaeriaceae in Italy. Plant Dis. 2021, 106, 1192–1202. [Google Scholar] [CrossRef]
- Moral, J.; Morgan, D.; Trapero, A.; Michailides, T.J. Ecology and epidemiology of diseases of nut crops and olives caused by Botryosphaeriaceae fungi in California and Spain. Plant Dis. 2019, 103, 1809–1827. [Google Scholar] [CrossRef] [PubMed] [Green Version]
- Moral, J.; Morgan, D.; Michailides, T.J. Management of Botryosphaeria canker and blight diseases of temperate zone nut crops. Crop Prot. 2019, 126, 104927. [Google Scholar]
- Gramaje, D.; Úrbez-Torres, J.R.; Sosnowski, M.R. Managing Grapevine Trunk Diseases with Respect to Etiology and Epidemiology: Current Strategies and Future Prospects. Plant Dis. 2018, 102, 12–39. [Google Scholar] [CrossRef] [PubMed] [Green Version]
- Medina, A.; Mohale, S.; Samsudin, N.I.P.; Rodriguez-Sixtos, A.; Rodriguez, A.; Magan, N. Biocontrol of mycotoxins: Dynamics and mechanisms of action. Curr. Opin. Food Sci. 2017, 17, 41–48. [Google Scholar] [CrossRef]
- Thambugala, K.M.; Daranagama, D.A.; Phillips, A.J.; Kannangara, S.D.; Promputtha, I. Fungi vs. fungi in biocontrol: An overview of fungal antagonists applied against fungal plant pathogens. Front. Cell. Infect. Microbiol. 2020, 10, 604923. [Google Scholar] [CrossRef] [PubMed]
- Sood, M.; Kapoor, D.; Kumar, V.; Sheteiwy, M.S.; Ramakrishnan, M.; Landi, M.; Araniti, F.; Sharma, A. Trichoderma: The “secrets” of a multitalented biocontrol agent. Plants 2020, 9, 762. [Google Scholar] [CrossRef]
- Ngalimat, M.S.; Yahaya, R.S.R.; Baharudin, M.M.A.A.; Yaminudin, S.M.; Karim, M.; Ahmad, S.A.; Sabri, S. A review on the biotechnological applications of the operational group Bacillus amyloliquefaciens. Microorganisms 2021, 9, 614. [Google Scholar] [CrossRef]
- Luo, Y.; Niederholzer, F.J.; Lightle, D.M.; Felts, D.; Lake, J.; Michailides, T.J. Limited Evidence for Accumulation of Latent Infections of Canker-Causing Pathogens in Shoots of Stone Fruit and Nut Crops in California. Phytopathology 2021, 111, 1963–1971. [Google Scholar] [CrossRef]
- Kucuk, C.; Kivanc, M. In vitro antifungal activity of strains of Trichoderma harzianum. Turk. J. Biol. 2004, 28, 111–115. [Google Scholar]
- Holland, L.A.; Travadon, R.; Lawrence, D.P.; Nouri, M.T.; Trouillas, F. Evaluation of Pruning Wound Protection Products for the Management of Almond Canker Diseases in California. Plant Dis. 2021, 105, 3368–3375. [Google Scholar] [CrossRef]
- Chen, W.-Q.; Morgan, D.P.; Felts, D.; Michailides, T.J. Antagonism of Paenibacillus lentimorbus to Botryosphaeria dothidea and biological control of panicle and shoot blight of pistachio. Plant Dis. 2003, 87, 359–365. [Google Scholar] [CrossRef] [PubMed] [Green Version]
- Torabi, A.; Bonjar, G.H.S.; Abdolshahi, R.; Pournamdari, M.; Saadoun, I.; Barka, E.A. Biological control of Paecilomyces formosus, the causal agent of dieback and canker diseases of pistachio by two strains of Streptomyces misionensis. Biol. Control 2019, 137, 104029. [Google Scholar] [CrossRef]
- Moradi, M.; Nejad, F.J.; Bonjar, G.H.S.; Fani, S.R.; Mimand, B.M.; Probst, C.; Madani, M. Efficacy of Bacillus subtilis native strains for biocontrol of Phytophthora crown and root rot of pistachio in Iran. Trop. Plant Pathol. 2018, 43, 306–313. [Google Scholar] [CrossRef]
- Moradi Pour, M.; Saberi Riseh, R.; Mohammadinejad, R.; Hosseini, A. Biological control of Phytophthora drechsleri the causal agent of pistachio gummosis by Bacillus subtilis (VRU1 strain) in green house condition. Pistachio Health J. 2019, 2, 53–61. [Google Scholar]
- Shahidi Bonjar, G.H.; Barkhordar, B.; Pakgohar, N.; Aghighi, S.; Biglary, S.; Rashid Farrokhi, P.; Aminaii, M.; Mahdavi, M.J.; Aghelizadeh, A. Biological control of Phytophthora drechsleri Tucker, the causal agent of pistachio gummosis, under greenhouse conditions by use of actinomycetes. Plant Pathol. J. 2006, 5, 20–23. [Google Scholar] [CrossRef] [Green Version]
- He, D.C.; He, M.H.; Amalin, D.M.; Liu, W.; Alvindia, D.G.; Zhan, J. Biological control of plant diseases: An evolutionary and eco-Economic consideration. Pathogens 2021, 10, 1311. [Google Scholar] [CrossRef]
- Adaskaveg, J.E.; Gubler, W.D.; Michailides, T.J. Fungicides, Bactericides, and Biologicals for Deciduous Tree Fruit, Nut, Strawberry, and Vine Crops, University of California Online Statewide IPM Program. 2017. Available online: http://ipm.ucanr.edu/PDF/PMG/fungicideefficacytiming.pdf (accessed on 5 March 2022).

| Treatment | First Assay y | ||||
|---|---|---|---|---|---|
| N. mediterraneum | N. hellenicum | B. dothidea | E. lata | L. pistaciae | |
| Control | 2.86 ± 0.06 a | 4.04 ± 0.02 a | 4.39 ± 0.14 a | 3.84 ± 0.07 a | 2.21 ± 0.02 ns |
| T. atroviride SC1 | 1.45 ± 0.03 b | 1.73 ± 0.14 b | 1.52 ± 0.10 b | 3.32 ± 0.09 b | 2.00 ± 0.29 |
| T. asperellum T34 | 1.37 ± 0.07 bc | 1.57 ± 0.31 b | 1.02 ± 0.12 b | 3.28 ± 0.07 b | 2.42 ± 0.22 |
| T. harzianum T22 | 1.10 ± 0.07 c | 2.08 ± 0.03 b | 1.45 ± 0.10 b | 3.72 ± 0.03 a | 1.78 ± 0.03 |
| Second Assay y | |||||
| N. mediterraneum | N. hellenicum | B. dothidea | E. lata | L. pistaciae | |
| Control | 3.80 ± 0.10 a | 4.53 ± 0.07 a | 4.08 ± 0.01 a | 4.84 ± 0.06 a | 1.95 ± 0.01 a |
| T. atroviride SC1 | 1.27 ± 0.02 c | 1.80 ± 0.05 c | 1.42 ± 0.06 b | 3.00 ± 0.00 c | 1.22 ± 0.07 c |
| T. asperellum T34 | 2.03 ± 0.07 b | 2.50 ± 0.10 b | 1.38 ± 0.03 b | 3.50 ± 0.08 b | 1.38 ± 0.02 bc |
| T. harzianum T22 | 1.38 ± 0.04 c | 2.78 ± 0.11 b | 1.50 ± 0.06 b | 3.57 ± 0.09 b | 1.47 ± 0.07 b |
| Treatment | First Assay y | ||||
|---|---|---|---|---|---|
| N. mediterraneum | N. hellenicum | B. dothidea | E. lata | L. pistaciae | |
| Control | 2.60 ± 0.15 ns | 4.00 ± 0.00 a | 4.17 ± 0.06 a | 4.82 ± 0.12 a | 2.38 ± 0.02 ns |
| B. amylo. QST713 | 2.05 ± 0.19 | 3.20 ± 0.15 b | 2.87 ± 0.12 b | 3.07 ± 0.03 b | 2.57 ± 0.07 |
| B. amylo. MBI600 | 2.03 ± 0.02 | 3.48 ± 0.16 ab | 2.68 ± 0.08 b | 2.72 ± 0.07 bc | 2.70 ± 0.05 |
| B. amylo. D747 | 2.05 ± 0.13 | 3.50 ± 0.06 ab | 2.85 ± 0.20 b | 2.58 ± 0.16 c | 2.43 ± 0.23 |
| Second Assay y | |||||
| N. mediterraneum | N. hellenicum | B. dothidea | E. lata | L. pistaciae | |
| Control | 3.80 ± 0.10 a | 4.53 ± 0.07 a | 4.08 ± 0.01 a | 4.84 ± 0.06 a | 1.95 ± 0.0 ns |
| B. amylo. QST713 | 2.40 ± 0.08 b | 2.70 ± 0.08 bc | 2.30 ± 0.05 b | 3.02 ± 0.06 b | 1.77 ± 0.10 |
| B. amylo. MBI600 | 2.48 ± 0.12 b | 2.83 ± 0.13 b | 2.47 ± 0.08 b | 3.22 ± 0.16 b | 2.00 ± 0.01 |
| B. amylo. D747 | 2.72 ± 0.15 b | 1.93 ± 0.32 c | 2.55 ± 0.08 b | 2.80 ± 0.15 b | 1.92 ± 0.07 |
| Factors | Average Lesion (cm) on Pistachio Twigs y | ||||||||||
|---|---|---|---|---|---|---|---|---|---|---|---|
| N. mediterraneum | N. hellenicum | B. dothidea | E. lata | L. pistaciae | |||||||
| Df | F | p Value | F | p Value | F | p Value | F | p Value | F | p Value | |
| Treatment | 6 | 0.987 | 0.4525 ns | 3.372 | 0.0125 | 0.767 | 0.6022 ns | 1.298 | 0.2902 ns | 3.636 | 0.0085 |
| Treatment × trial | 6 | 0.640 | 0.6970 ns | 1.296 | 0.2914 ns | 1.290 | 0.2936 ns | 0.730 | 0.6290 ns | 1.952 | 0.1069 ns |
| Treatment | Average Lesion (cm) on Pistachio Twigs | ||||
|---|---|---|---|---|---|
| N. mediterraneum | N. hellenicum | B. dothidea | E. lata | L.pistaciaey | |
| Control | 14.29 ± 0.29 ns | 14.46 ± 0.29 a | 12.50 ± 0.67 ns | 7.75 ± 1.25 ns | 1.27 ± 0.15 a |
| T. asperellum T34 | 14.21 ± 0.87 | 13.87 ± 0.29 ab | 13.83 ± 1.50 | 5.23 ± 1.97 | 1.07 ± 0.02 ab |
| T. harzianum T22 | 14.83 ± 1.00 | 11.79 ± 1.29 b | 11.58 ± 0.25 | 2.81 ± 0.44 | 1.13 ± 0.05 ab |
| T. atroviride SC1 | 12.33 ± 0.33 | 13.33 ± 1.00 ab | 12.46 ± 1.37 | 2.54 ± 0.54 | 1.17 ± 0.33 ab |
| B. amylo. QST713 | 13.58 ± 0.67 | 12.37 ± 0.62 ab | 11.71 ± 0.21 | 4.07 ± 0.85 | 0.91 ± 0.29 ab |
| B. amylo. MBI600 | 13.96 ± 0.04 | 13.52 ± 0.65 ab | 12.08 ± 0.67 | 5.62 ± 1.12 | 0.66 ± 0.01 ab |
| B. amylo. D747 | 13.95 ± 0.08 | 12.75 ± 0.08 ab | 12.00 ± 0.83 | 4.77 ± 1.73 | 0.59 ± 0.02 b |
| Factor(s) | Fruit Decay Caused by Neofusicoccum mediterraneum y | ||||
|---|---|---|---|---|---|
| Lesion Diameter (cm) | Lesion Surface (cm2) | ||||
| df | F | p value | F | p value | |
| Treatment | 12 | 4.200 | 0.000134 | 8.1796 | 0.000000 |
| Trial | 1 | 1.926 | 0.171124 ns | 1.4758 | 0.229914 ns |
| Treatment × trial | 12 | 0.862 | 0.588410 ns | 1.3170 | 0.237622 ns |
| Treatment | Fruit Decay Amount y | |
|---|---|---|
| Mean Diam. (cm) | Mean Area (cm2) | |
| Control | 1.81 ± 0.17 a | 2.53 ± 0.49 a |
| Bacillus amyloliquefaciens MBI600 (low dosage) | 1.27 ± 0.03 ab | 1.01 ± 0.12 b |
| Bacillus amyloliquefaciens QST713 (low dosage) | 1.22 ± 0.04 b | 0.94 ± 0.10 b |
| Trichoderma harzianum T22 (low dosage) | 1.22 ± 0.05 b | 0.97 ± 0.12 b |
| Trichoderma harzianum T34 (low dosage) | 1.22 ± 0.04 b | 0.98 ± 0.09 b |
| Bacillus amyloliquefaciens D747 (low dosage) | 1.17 ± 0.03 b | 0.92 ± 0.11 b |
| Trichoderma atroviride SC1 (low dosage) | 1.11 ± 0.004 b | 0.92 ± 0.01 b |
| Bacillus amyloliquefaciens MBI600 (medium dosage) | 1.05 ± 0.08 b | 0.78 ± 0.10 b |
| Bacillus amyloliquefaciens QST713 (medium dosage) | 1.05 ± 0.01 b | 0.70 ± 0.01 b |
| Trichoderma atroviride SC1 (medium dosage) | 1.05 ± 0.22 b | 0.75 ± 0.34 b |
| Trichoderma harzianum T22 (medium dosage) | 0.97 ± 0.02 b | 0.60 ± 0.01 b |
| Trichoderma harzianum T34 (medium dosage) | 0.92 ± 0.02 b | 0.64 ± 0.04 b |
| Bacillus amyloliquefaciens D747 (medium dosage) | 0.91 ± 0.25 b | 0.77 ± 0.28 b |
| Active Ingredient | Trade Name | Rates (g or mL/1000 L) | |
|---|---|---|---|
| Low | Medium | ||
| Bacillus amyloliquefaciens QST713 (formerly B. subtilis) | Serenade® Aso | 2700 | 5300 |
| Bacillus amyloliquefaciens ssp. plantarum D747 | Amylo-X® LC | 2000 | 3500 |
| Bacillus amyloliquefaciens MBI600 | Serifel® | 500 | 1000 |
| Trichoderma harzianum T-22 | Trianum-P® | 2500 | 5000 |
| Trichoderma asperellum T34 | T34 Biocontrol® | 10 | 500 |
| Trichoderma atroviride SC1 | Vintec® | 1000 | 2000 |
Publisher’s Note: MDPI stays neutral with regard to jurisdictional claims in published maps and institutional affiliations. |
© 2022 by the authors. Licensee MDPI, Basel, Switzerland. This article is an open access article distributed under the terms and conditions of the Creative Commons Attribution (CC BY) license (https://creativecommons.org/licenses/by/4.0/).
Share and Cite
Gusella, G.; Vitale, A.; Polizzi, G. Potential Role of Biocontrol Agents for Sustainable Management of Fungal Pathogens Causing Canker and Fruit Rot of Pistachio in Italy. Pathogens 2022, 11, 829. https://doi.org/10.3390/pathogens11080829
Gusella G, Vitale A, Polizzi G. Potential Role of Biocontrol Agents for Sustainable Management of Fungal Pathogens Causing Canker and Fruit Rot of Pistachio in Italy. Pathogens. 2022; 11(8):829. https://doi.org/10.3390/pathogens11080829
Chicago/Turabian StyleGusella, Giorgio, Alessandro Vitale, and Giancarlo Polizzi. 2022. "Potential Role of Biocontrol Agents for Sustainable Management of Fungal Pathogens Causing Canker and Fruit Rot of Pistachio in Italy" Pathogens 11, no. 8: 829. https://doi.org/10.3390/pathogens11080829
APA StyleGusella, G., Vitale, A., & Polizzi, G. (2022). Potential Role of Biocontrol Agents for Sustainable Management of Fungal Pathogens Causing Canker and Fruit Rot of Pistachio in Italy. Pathogens, 11(8), 829. https://doi.org/10.3390/pathogens11080829

